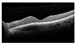
Jcm 14 02849 i021

Stabilizing Macular Edema Fluctuations: Outcomes of Intravitreal Fluocinolone Acetonide for Diabetic Macular Edema and Non-Infectious Uveitis
Abstract
1. Introduction
2. Materials and Methods
2.1. Study Design
2.2. Study Outcomes
2.3. Data Analyses
3. Results
3.1. Baseline Demographics
3.2. Cohort 1: Patients with DME
3.2.1. Central Retinal Thickness
3.2.2. Visual Acuity
3.2.3. Safety Outcomes Measures and Cataract-Related Events
3.3. Cohort 2: Patients with NIU-PS
3.3.1. Central Retinal Thickness
3.3.2. Visual Acuity
3.3.3. Safety Outcomes Measures and Cataract-Related Events
3.3.4. Other Adverse Events
3.4. Supplementary Treatments
3.4.1. Cohort 1: Patients with DME
3.4.2. Cohort 2: Patients with NIU-PS
3.5. Reinjections of FA Implants
3.6. Case Presentations
3.6.1. Patient A: DME (OS)
3.6.2. Patient B: Birdshot Retinopathy (OS and OD)
4. Discussion
Supplementary Materials
Author Contributions
Funding
Institutional Review Board Statement
Informed Consent Statement
Data Availability Statement
Conflicts of Interest
Abbreviations
| BCVA | Best-corrected visual acuity |
| CME | Chronic macular edema |
| CRT | Central retinal thickness |
| DME | Diabetic macular edema |
| FA | Fluocinolone acetonide |
| IOP | Intraocular pressure |
| NIU-PS | Non-infectious uveitis affecting the posterior segment |
| OCT | Optical coherence tomography |
| OD | Oculus dexter |
| OS | Oculus sinister |
| SD | Standard deviation |
| SEM | Standard error mean |
| TNF | Tumor necrosis factor |
| VA | Visual acuity |
| VEGF | Vascular endothelial growth factor |
References
- Magliano, D.J.; Boyko, E.J. IDF Diabetes Atlas, 10th ed.; International Diabetes Federation: Brussels, Belgium, 2021. [Google Scholar]
- Kraatz, K.; Neu, A.; Kröger, J.; Seidel-Jacobs, E.; Tönnies, T.; Rathmann, W.; Schulze, M.; Kabisch, S.; Sachno, A.; Ramich, O.; et al. Deutscher Gesundheitsreport Diabetes; Deutsche Diabetes Gesellschaft (DDG) und diabetes DE–Deutsche Diabetes-Hilfe: Berlin, Germany, 2023; ISSN 1614-824X. [Google Scholar]
- Ong, K.L.; Stafford, L.K.; McLaughlin, S.A.; Boyko, E.J.; Vollset, S.E.; Smith, A.E.; Dalton, B.E.; Duprey, J.; Cruz, J.A.; Hagins, H.; et al. Global, Regional, and National Burden of Diabetes from 1990 to 2021, with Projections of Prevalence to 2050: A Systematic Analysis for the Global Burden of Disease Study 2021. Lancet 2023, 402, 203–234. [Google Scholar] [CrossRef] [PubMed]
- Dong, N.; Xu, B.; Wang, B.; Chu, L. Study of 27 Aqueous Humor Cytokines in Patients with Type 2 Diabetes with or without Retinopathy. Mol. Vis. 2013, 19, 1734–1746. [Google Scholar]
- Noma, H.; Yasuda, K.; Shimura, M. Involvement of Cytokines in the Pathogenesis of Diabetic Macular Edema. Int. J. Mol. Sci. 2021, 22, 3427. [Google Scholar] [CrossRef] [PubMed]
- Durrani, O.M.; Meads, C.A.; Murray, P.I. Uveitis: A Potentially Blinding Disease. Ophthalmologica 2004, 218, 223–236. [Google Scholar] [CrossRef] [PubMed]
- Rosenbaum, J.T.; Bodaghi, B.; Couto, C.; Zierhut, M.; Acharya, N.; Pavesio, C.; Tay-Kearney, M.L.; Neri, P.; Douglas, K.; Pathai, S.; et al. New Observations and Emerging Ideas in Diagnosis and Management of Non-Infectious Uveitis: A Review. Semin. Arthritis Rheum. 2019, 49, 438–445. [Google Scholar] [CrossRef]
- Tsirouki, T.; Dastiridou, A.; Symeonidis, C.; Tounakaki, O.; Brazitikou, I.; Kalogeropoulos, C.; Androudi, S. A Focus on the Epidemiology of Uveitis. Ocul. Immunol. Inflamm. 2018, 26, 2–16. [Google Scholar] [CrossRef]
- Pleyer, U.; Neri, P.; Deuter, C. New Pharmacotherapy Options for Noninfectious Posterior Uveitis. Int. Ophthalmol. 2021, 41, 2265–2281. [Google Scholar] [CrossRef]
- Sivaprasad, S.; Oyetunde, S. Impact of Injection Therapy on Retinal Patients with Diabetic Macular Edema or Retinal Vein Occlusion. Clin. Ophthalmol. 2016, 10, 939–946. [Google Scholar] [CrossRef]
- Ehlken, C.; Ziemssen, F.; Eter, N.; Lanzl, I.; Kaymak, H.; Lommatzsch, A.; Schuster, A.K. Systematic Review: Non-Adherence and Non-Persistence in Intravitreal Treatment. Graefe’s Arch. Clin. Exp. Ophthalmol. 2020, 258, 2077–2090. [Google Scholar] [CrossRef]
- Weiss, M.; Sim, D.A.; Herold, T.; Schumann, R.G.; Liegl, R.; Kern, C.; Kreutzer, T.; Schiefelbein, J.; Rottmann, M.; Priglinger, S.; et al. Complicance and Adherence of Patients with Diabetic Macular Edema to Intravitreal Anti-Vascular Endothelial Growth Factor Therapy in Daily Practice. Retina 2018, 38, 2293–2300. [Google Scholar] [CrossRef]
- Daruich, A.; Matet, A.; Moulin, A.; Kowalczuk, L.; Nicolas, M.; Sellam, A.; Rothschild, P.R.; Omri, S.; Gélizé, E.; Jonet, L.; et al. Mechanisms of Macular Edema: Beyond the Surface. Prog. Retin. Eye Res. 2018, 63, 20–68. [Google Scholar] [CrossRef] [PubMed]
- Perez, V.L.; Caspi, R.R. Immune Mechanisms in Inflammatory and Degenerative Eye Disease. Trends Immunol. 2015, 36, 354–363. [Google Scholar] [CrossRef] [PubMed]
- Riemann, C.D.; Eaton, A.M.; Cutino, A. Reduction in Retinal Thickness Fluctuations after Treatment with Fluocinolone Acetonide Implant for DME: A Post-Hoc Analysis of the User Study. Ophthalmic Surg. Lasers Imaging Retin. 2020, 51, 298–306. [Google Scholar] [CrossRef]
- Starr, M.R.; Salabati, M.; Mahmoudzadeh, R.; Patel, L.G.; Ammar, M.J.; Hsu, J.; Garg, S.; Ho, A.C.; Kuriyan, A.E. Fluctuations in Central Subfield Thickness Associated With Worse Visual Outcomes in Patients With Diabetic Macular Edema in Clinical Trial Setting. Am. J. Ophthalmol. 2021, 232, 90–97. [Google Scholar] [CrossRef]
- Torjani, A.; Mahmoudzadeh, R.; Salabati, M.; Cai, L.; Hsu, J.; Garg, S.; Ho, A.C.; Yonekawa, Y.; Kuriyan, A.E.; Starr, M.R. Factors Associated with Fluctuations in Central Subfield Thickness in Patients with Diabetic Macular Edema Using Diabetic Retinopathy Clinical Research Protocols T and V. Ophthalmol. Sci. 2023, 3, 100226. [Google Scholar] [CrossRef] [PubMed]
- Campochiaro, P.A.; Nguyen, Q.D.; Hafiz, G.; Bloom, S.; Brown, D.M.; Busquets, M.; Ciulla, T.; Feiner, L.; Sabates, N.; Billman, K.; et al. Aqueous Levels of Fluocinolone Acetonide after Administration of Fluocinolone Acetonide Inserts or Fluocinolone Acetonide Implants. Ophthalmology 2013, 120, 583–587. [Google Scholar] [CrossRef]
- Deuchler, S.K.; Schubert, R.; Singh, P.; Chedid, A.; Kenikstul, N.; Scott, J.; Kohnen, T.; Ackermann, H.; Koch, F. Vitreous Cytokine Levels Following the Administration of a Single 0.19 Mg Fluocinolone Acetonide (ILUVIEN®) Implant in Patients with Refractory Diabetic Macular Edema (DME)—Results from the ILUVIT Study. Graefe’s Arch. Clin. Exp. Ophthalmol. 2022, 260, 2537–2547. [Google Scholar] [CrossRef]
- Wykoff, C.C.; Chakravarthy, U.; Campochiaro, P.A.; Bailey, C.; Green, K.; Cunha-Vaz, J. Long-Term Effects of Intravitreal 0.19 Mg Fluocinolone Acetonide Implant on Progression and Regression of Diabetic Retinopathy. Ophthalmology 2017, 124, 440–449. [Google Scholar] [CrossRef]
- Khoramnia, R.; Peto, T.; Koch, F.; Taylor, S.R.; Castro De Sousa, J.P.; Hill, L.; Bailey, C.; Chakravarthy, U. Clinical Science Safety and Effectiveness of the Fluocinolone Acetonide Intravitreal Implant (ILUVIEN): 3-Year Results from the European IRISS Registry Study. Br. J. Ophthalmol. 2022, 107, 1502–1508. [Google Scholar] [CrossRef]
- Campochiaro, P.A.; Brown, D.M.; Pearson, A.; Chen, S.; Boyer, D.; Ruiz-Moreno, J.; Garretson, B.; Gupta, A.; Hariprasad, S.M.; Bailey, C.; et al. Sustained Delivery Fluocinolone Acetonide Vitreous Inserts Provide Benefit for at Least 3 Years in Patients with Diabetic Macular Edema. Ophthalmology 2012, 119, 2125–2132. [Google Scholar] [CrossRef]
- Buhl, L.; Thurau, S.; Kern, C. Fluocinolone Acetonide 0.19-Mg Implant for the Treatment of Noninfectious Uveitis with Involvement of the Posterior Segment: A Real-World Study. Graefe’s Arch. Clin. Exp. Ophthalmol. 2022, 261, 1101–1108. [Google Scholar] [CrossRef]
- Jaffe, G.J.; Pavesio, C.E. Effect of a Fluocinolone Acetonide Insert on Recurrence Rates in Noninfectious Intermediate, Posterior, or Panuveitis: Three-Year Results. Ophthalmology 2020, 127, 1395–1404. [Google Scholar] [CrossRef] [PubMed]
- Pavesio, C.; Heinz, C. Non-Infectious Uveitis Affecting the Posterior Segment Treated with Fluocinolone Acetonide Intravitreal Implant: 3-Years Fellow Eye Analysis. Eye 2021, 36, 1231–1237. [Google Scholar] [CrossRef] [PubMed]
- Hikal, M.; Celik, N.; Auffarth, G.U.; Khoramnia, R.; Kessler, L.J.; Mayer, C.S. Intravitreal 0.19 Mg Fluocinolone Acetonide Implant in Non-Infectious Uveitis. J. Clin. Med. 2021, 10, 3966. [Google Scholar] [CrossRef] [PubMed]
- Augustin, A.J.; Bopp, S.; Fechner, M.; Holz, F.; Sandner, D.; Winkgen, A.M.; Khoramnia, R.; Neuhann, T.; Warscher, M.; Spitzer, M.; et al. Three-Year Results from the Retro-IDEAL Study: Real-World Data from Diabetic Macular Edema (DME) Patients Treated with ILUVIEN® (0.19 Mg Fluocinolone Acetonide Implant). Eur. J. Ophthalmol. 2020, 30, 382–391. [Google Scholar] [CrossRef]
- Buhl, L.; Schmelter, V.; Schworm, B.; Thurau, S.; Kern, C. Long-Term Results of 0.19mg Fluocinolone Acetonide Insert for Treatment of Non-Infectious Uveitis in Clinical Practice. Ocul. Immunol. Inflamm. 2023, 32, 1395–1399. [Google Scholar] [CrossRef]
- Schechet, S.A.; Adams, O.E.; Eichenbaum, D.A.; Hariprasad, S.M. Macular Thickness Amplitude Changes When Switching from Discontinuous to Continuous Therapy for Diabetic Macular Oedema. BMJ Open Ophthalmol. 2019, 4, e000271. [Google Scholar] [CrossRef]
- Holden, S.E.; Habib, M.; Currie, C.J. Retinal Thickness Fluctuations in Patients Receiving Fluocinolone Acetonide Implant for Diabetic Macular Edema. Curr. Med. Res. Opin. 2020, 36, 959–965. [Google Scholar] [CrossRef]
- Singer, M.A.; Sheth, V.; Mansour, S.E.; Coughlin, B.; Gonzalez, V.H. Three-Year Safety and Efficacy of the 0.19-Mg Fluocinolone Acetonide Intravitreal Implant for Diabetic Macular Edema: The PALADIN Study. Ophthalmology 2022, 129, 605–613. [Google Scholar] [CrossRef]
- Sheth, V.S.; Singer, M.; MacCumber, M.; Cutino, A.; Kasper, J.; Coughlin, B.A.; Riemann, C.D. Long-Term Control of Retinal Thickness Variability and Vision Following the 0.19 Mg Fluocinolone Acetonide Implant. J. Vitr. Dis. 2023, 7, 490–497. [Google Scholar] [CrossRef]
- Diabetic Retinopathy Clinical Research Network; Browning, D.J.; Glassman, A.R.; Aiello, L.P.; Beck, R.W.; Brown, D.M.; Fong, D.S.; Bressler, N.M.; Danis, R.P.; Kinyoun, J.L.; et al. Relationship between Optical Coherence Tomography-Measured Central Retinal Thickness and Visual Acuity in Diabetic Macular Edema. Ophthalmology 2007, 114, 525–536. [Google Scholar] [CrossRef] [PubMed]
- Kodjikian, L.; Baillif, S.; Creuzot-Garcher, C.; Delyfer, M.N.; Matonti, F.; Weber, M.; Mathis, T. Real-World Efficacy and Safety of Fluocinolone Acetonide Implant for Diabetic Macular Edema: A Systematic Review. Pharmaceutics 2021, 13, 72. [Google Scholar] [CrossRef] [PubMed]
- Tomkins-Netzer, O.; Lightman, S.L.; Burke, A.E.; Sugar, E.A.; Lim, L.L.; Jaffe, G.J.; Altaweel, M.M.; Kempen, J.H.; Holbrook, J.T.; Jabs, D.A. Seven-Year Outcomes of Uveitic Macular Edema: The Multicenter Uveitis Steroid Treatment Trial and Follow-up Study Results. Ophthalmology 2021, 128, 719–728. [Google Scholar] [CrossRef] [PubMed]
- Wang, V.Y.; Kuo, B.L.; Chen, A.X.; Wang, K.; Greenlee, T.E.; Conti, T.F.; Singh, R.P. Fluctuations in Macular Thickness in Patients with Diabetic Macular Oedema Treated with Anti-Vascular Endothelial Growth Factor Agents. Eye 2022, 36, 1461–1467. [Google Scholar] [CrossRef]
- Singh, P.; Chedid, A.; Deuchler, S.K.; Kohnen, T.; Müller, M.; Koch, F.H. The Efficacy and Safety Outcomes of the 0.19 Mg Fluocinolone Acetonide Implant after Prior Treatment with the 0.7 Mg Dexamethasone Implant in Patients with Diabetic Macular Edema. Int. Med. Case Rep. J. 2018, 11, 265–269. [Google Scholar] [CrossRef]
- McGregor, F.; Dick, A.D.; Burke, T. Achieving Quiescence with Fluocinolone Implants. Case Rep. Ophthalmol. 2021, 12, 356–362. [Google Scholar] [CrossRef]
- Bodaghi, B.; Nguyen, Q.D.; Jaffe, G.; Khoramnia, R.; Pavesio, C. Preventing Relapse in Non-Infectious Uveitis Affecting the Posterior Segment of the Eye—Evaluating the 0.2 Μg/Day Fluocinolone Acetonide Intravitreal Implant (ILUVIEN®). J. Ophthalmic. Inflamm. Infect. 2020, 10, 32. [Google Scholar] [CrossRef]
- Rehak, M.; Busch, C.; Unterlauft, J.D.; Jochmann, C.; Wiedemann, P. Outcomes in Diabetic Macular Edema Switched Directly or after a Dexamethasone Implant to a Fluocinolone Acetonide Intravitreal Implant Following Anti-VEGF Treatment. Acta Diabetol. 2020, 57, 469–478. [Google Scholar] [CrossRef]
- Abu Arif, J.; Knecht, V.A.; Rübsam, A.; Lussac, V.; Jami, Z.; Pohlmann, D.; Müller, B.; Pleyer, U. Fluocinolone Acetonide Implant for Uveitis: Dissecting Responder and Non-Responder Outcomes at a Tertiary Center. Biomedicines 2024, 12, 1106. [Google Scholar] [CrossRef]
- Eaton, A.; Koh, S.S.; Jimenez, J.; Riemann, C.D. The USER Study: A Chart Review of Patients Receiving a 0.2 Lg/Day Fluocinolone Acetonide Implant for Diabetic Macular Edema. Ophthalmol. Ther. 2019, 8, 51–62. [Google Scholar] [CrossRef]
- Wu, X.; Tao, M.; Zhu, L.; Zhang, T.; Zhang, M. Pathogenesis and Current Therapies for Non-Infectious Uveitis. Clin. Exp. Med. 2023, 23, 1089–1106. [Google Scholar] [CrossRef] [PubMed]
- Glassman, A.R.; Wells, J.A.; Josic, K.; Maguire, M.G.; Antoszyk, A.N.; Baker, C.; Beaulieu, W.T.; Elman, M.J.; Jampol, L.M.; Sun, J.K. Five-Year Outcomes after Initial Aflibercept, Bevacizumab, or Ranibizumab Treatment for Diabetic Macular Edema (Protocol T Extension Study). Ophthalmology 2020, 127, 1201–1210. [Google Scholar] [CrossRef] [PubMed]




| Baseline Demographics | DME | NIU-PS |
|---|---|---|
| Number of eyes | 21 | 25 |
| Number of patients | 18 | 18 |
| Mean age ± SD (years) | 66.6 ± 5.9 | 55.0 ± 11.4 |
| Sex (n (%)) | ||
| Female | 9 (42.9) | 21 (84.0) |
| Male | 12 (57.1) | 4 (16.0) |
| Mean BCVA ± SD | 0.25 ± 0.17 | 0.34 ± 0.26 |
| Mean IOP ± SD (mmHg) | 14.5 ± 3.6 | 13.8 ± 2.8 |
| Lens status (n (%)) | ||
| Phakic | 5 (23.8) | 9 (36.0) |
| Pseudophakic | 16 (76.2) | 16 (64.0) |
| Aphakic | 0 (0.0) | 0 (0.0) |
| Previous treatment (intravitreal or intraocular) (n (%)) | ||
| Anti-VEGF only | 5 (23.8) | 0 (0.0) |
| Anti-VEGF and steroids | 9 (42.9) | 1 (4.0) |
| Anti-VEGF and laser | 2 (9.5) | 0 (0.0) |
| Anti-VEGF, laser, and steroids | 2 (9.5) | 0 (0.0) |
| Steroids only | 2 (9.5) | 21 (84.0) |
| Unknown or no previous treatment | 1 (4.8) | 2/1 (12.0) |
| Non-infectious uveitis with involvement of posterior segment (n (%)) | ||
| Anterior | / | 0 (0.0) |
| Intermediate | / | 2 (8.0) |
| Posterior | / | 21 (84.0) |
| Panuveitis | / | 2 (8.0) |
| Supplementary Intravitreal Treatments within 36 Months | DME (n = 21) | NIU-PS (n = 25) |
|---|---|---|
| Eyes with supplementary treatments (n (%)) | 9 (42.9) | 5 (20.0) |
| Type of supplementary treatments (n eyes (% of total eyes with supplementary treatments)) | ||
| Intravitreal steroids | 5 (55.6) | 2 (40.0) |
| Intravitreal anti-VEGF | 7 (77.8) | 4 (16.0) |
| Laser therapy | 3 (33.3) | 0 (0.0) |
| Combination of different treatments | 3 (33.3) | 1 (20.0) |
| Number of treatments (mean ± SD) | 4.6 ± 4.1 | 4.8 ± 5.4 |
| Date | Visual Acuity | CRT (µm) | OCT | Treatment |
|---|---|---|---|---|
| April 2016 | 0.4 | 489 | ![]() | 1. FA implant (07/2016) |
| August 2016 | 0.4 | 178 | ![]() | |
| October 2016 | 0.4 | 179 | ![]() | |
| August 2017 | 0.5 | 184 | ![]() | |
| February 2018 | 0.3 | 182 | ![]() | |
| June 2019 | 0.4 | 181 | ![]() | 2. FA implant (12/2019) |
| January 2020 | 0.4 | 176 | ![]() | |
| February 2021 | 0.4 | 185 | ![]() | |
| July 2021 | 0.4 | 177 | ![]() | |
| January 2022 | 0.4 | 188 | ![]() |
| OS | OD | |||||||
|---|---|---|---|---|---|---|---|---|
| Date | Visual Acuity | CRT (µm) | OCT | Treatment | Visual Acuity | CRT (µm) | OCT | Treatment |
| February 2014 | 0.1 | 391 | ![]() | 1. FA implant (05/2014) | 0.1 | 568 | ![]() | 1. FA implant (04/2014) |
| June 2014 | 0.1 | 176 | ![]() | 0.15 | 167 | ![]() | ||
| October 2014 | 0.16 | 160 | ![]() | 0.2 | 159 | ![]() | ||
| March 2015 | 0.1 | 159 | ![]() | 0.1 | 162 | ![]() | ||
| October 2015 | 0.2 | 158 | ![]() | 0.3 | 168 | ![]() | ||
| December 2016 | 0.4 | 156 | ![]() | 0.3 | 181 | ![]() | ||
| October 2017 | 0.25 | 153 | ![]() | 0.25 | 418 | ![]() | 2. FA implant (01/2018) | |
| February 2018 | 0.5 | 151 | ![]() | 0.3 | 187 | ![]() | ||
| March 2019 | 0.5 | 154 | ![]() | 0.4 | 169 | ![]() | ||
| October 2019 | / | / | / | 0.4 | 166 | ![]() | ||
| October 2020 | 0.2 | 155 | ![]() | 0.2 | 166 | ![]() | ||
| October 2021 | 0.4 | 149 | ![]() | 0.4 | 163 | ![]() | 3. FA implant (12/2021) | |
| March 2022 | 0.5 | 148 | ![]() | 0.5 | 158 | ![]() | ||
Disclaimer/Publisher’s Note: The statements, opinions and data contained in all publications are solely those of the individual author(s) and contributor(s) and not of MDPI and/or the editor(s). MDPI and/or the editor(s) disclaim responsibility for any injury to people or property resulting from any ideas, methods, instructions or products referred to in the content. |
© 2025 by the authors. Licensee MDPI, Basel, Switzerland. This article is an open access article distributed under the terms and conditions of the Creative Commons Attribution (CC BY) license (https://creativecommons.org/licenses/by/4.0/).
Share and Cite
Hohberger, B.; Royer, M.; Flamann, C.S.; Bergua, A. Stabilizing Macular Edema Fluctuations: Outcomes of Intravitreal Fluocinolone Acetonide for Diabetic Macular Edema and Non-Infectious Uveitis. J. Clin. Med. 2025, 14, 2849. https://doi.org/10.3390/jcm14082849
Hohberger B, Royer M, Flamann CS, Bergua A. Stabilizing Macular Edema Fluctuations: Outcomes of Intravitreal Fluocinolone Acetonide for Diabetic Macular Edema and Non-Infectious Uveitis. Journal of Clinical Medicine. 2025; 14(8):2849. https://doi.org/10.3390/jcm14082849
Chicago/Turabian StyleHohberger, Bettina, Melanie Royer, Cindy Sheree Flamann, and Antonio Bergua. 2025. "Stabilizing Macular Edema Fluctuations: Outcomes of Intravitreal Fluocinolone Acetonide for Diabetic Macular Edema and Non-Infectious Uveitis" Journal of Clinical Medicine 14, no. 8: 2849. https://doi.org/10.3390/jcm14082849
APA StyleHohberger, B., Royer, M., Flamann, C. S., & Bergua, A. (2025). Stabilizing Macular Edema Fluctuations: Outcomes of Intravitreal Fluocinolone Acetonide for Diabetic Macular Edema and Non-Infectious Uveitis. Journal of Clinical Medicine, 14(8), 2849. https://doi.org/10.3390/jcm14082849